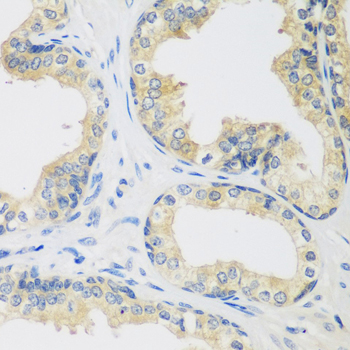
Immunohistochemistry - UPF2 Polyclonal Antibody

-
Product Name
UPF2 Polyclonal Antibody
- Documents
-
Description
Polyclonal antibody to UPF2
-
Tested applications
WB, IHC
-
Species reactivity
Human, Mouse, Rat
-
Alternative names
UPF2 antibody; HUPF2 antibody; RENT2 antibody; smg-3 antibody; regulator of nonsense transcripts 2 antibody
-
Isotype
Rabbit IgG
-
Preparation
Antigen: Recombinant fusion protein containing a sequence corresponding to amino acids 1153-1272 of human UPF2 (NP_542166.1).
-
Clonality
Polyclonal
-
Formulation
PBS with 0.02% sodium azide, 50% glycerol, pH7.3.
-
Storage instructions
Store at -20℃. Avoid freeze / thaw cycles.
-
Applications
WB 1:500 - 1:2000
IHC 1:50 - 1:200 -
Validations

Western blot - UPF2 Polyclonal Antibody
Western blot analysis of extracts of various cell lines, using UPF2 antibody at 1:1000 dilution.Secondary antibody: HRP Goat Anti-Rabbit IgG (H+L) at 1:10000 dilution.Lysates/proteins: 25ug per lane.Blocking buffer: 3% nonfat dry milk in TBST.Detection: ECL Basic Kit .Exposure time: 90s.

Immunohistochemistry - UPF2 Polyclonal Antibody
Immunohistochemistry of paraffin-embedded human lung using UPF2 antibody at dilution of 1:100 (40x lens).
Immunohistochemistry - UPF2 Polyclonal Antibody
Immunohistochemistry of paraffin-embedded human prostate using UPF2 antibody at dilution of 1:100 (40x lens).
-
Background
Involved in nonsense-mediated decay (NMD) of mRNAs containing premature stop codons by associating with the nuclear exon junction complex (EJC). Recruited by UPF3B associated with the EJC core at the cytoplasmic side of the nuclear envelope and the subsequent formation of an UPF1-UPF2-UPF3 surveillance complex (including UPF1 bound to release factors at the stalled ribosome) is believed to activate NMD. In cooperation with UPF3B stimulates both ATPase and RNA helicase activities of UPF1. Binds spliced mRNA.
Related Products / Services
Please note: All products are "FOR RESEARCH USE ONLY AND ARE NOT INTENDED FOR DIAGNOSTIC OR THERAPEUTIC USE"
